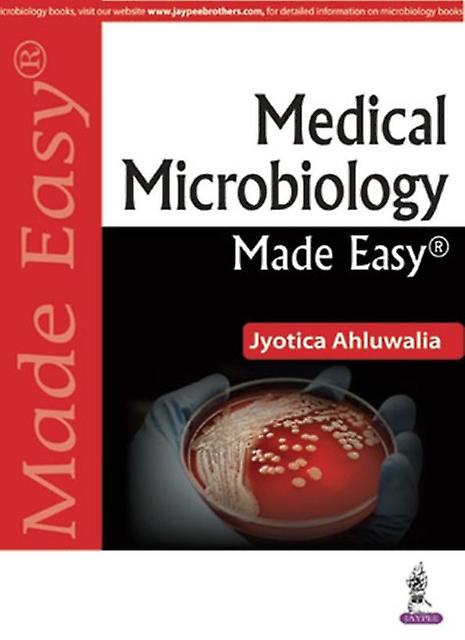

Medical Microbiology Made Easy - Jyotica Ahluwalia - Paperback - English Book - Other branches of medicine
- 品牌: Unbranded
Medical Microbiology Made Easy - Jyotica Ahluwalia - Paperback - English Book - Other branches of medicine
- 品牌: Unbranded
14天退货政策
14天退货政策
付款方式:
描述
Medical Microbiology Made Easy - Jyotica Ahluwalia - Paperback - English Book - Other branches of medicine
- 品牌: Unbranded
- 类别: 科学、 医学与自然
-
语言: English
-
作者: Jyotica Ahluwalia
-
页数: 430
-
出版社/标签: Jaypee Brothers Medical Publishers
-
格式: Paperback
- Fruugo ID: 53871112-108952148
- ISBN: 9789352700974
配送 & 退货
在 24 小时内发货
-
STANDARD: CN¥86.99 - 之间的交付 周三 04 二月 2026–周二 10 二月 2026
从 英国 送货。
我们会争取将您订购的产品按照您的规格完整地配送给您。不过,万一您收到不完整的订单,或收到的产品与您订购的不同,或者有其他原因让您对订单不满意,您可以要求全部或部分退货,您将收到相应产品的全额退款。 查看完整的退货政策
